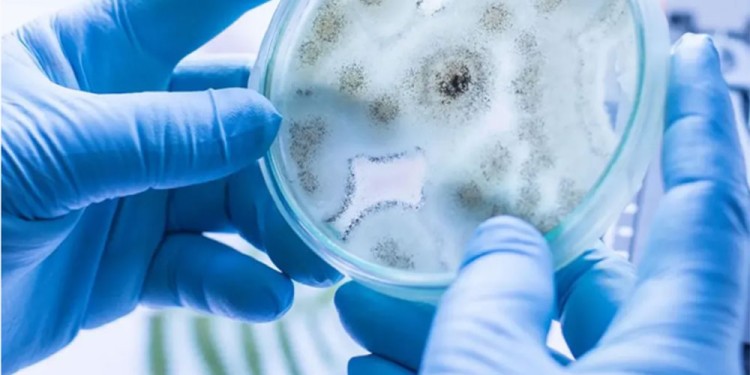
Foto: NA
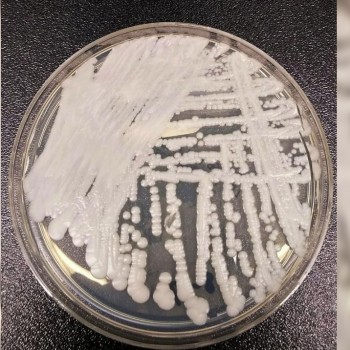

Frente a los recientes casos de Candida Auris detectados en el país, surge la necesidad de saber por qué cabe prestarle puntual atención a este hongo, además de que las entidades oficiales de la Salud han establecido una alarma al respecto. ¿Puede afectar a cualquier persona? ¿Cómo se contagia? ¿Es mortal?
En comunicación con la FM Santa María de las Misiones, la doctora Liliana Arce, quien es médica pediatra e infectóloga, y actualmente se desempeña como jefa del Servicio Infectología del Hospital Fernando Barreyro, describió cuáles son las características de este hongo y cómo proceder para prevenirlo.
Quizás la denominación “super hongo” guarda cierta relación con la capacidad de este patógeno de ser muy resistente a los medicamentos:
“Hay tres líneas de antimicóticos o medicamentos para hongos. El problema es que el 30% de esta Candida Auris está siendo resistente a algunos de ellos, y hay un porcentaje pequeño pero sumamente importante, que es resistente a las tres líneas de antifúngico”, explicó la especialista.
Ese es uno de los motivos por el cual la Organización Mundial de la Salud ha fijado una alarma que se hace extensiva a otras entidades; además de que han determinado la “emergencia de 19 hongos”. Un dato no menor es que la infección por este hongo implica un porcentaje del 30% a 70% de probabilidad de mortalidad.
Mencionó que circulan casos en aproximadamente cincuenta países, y en Latinoamérica se registraron en Colombia, Brasil y durante los últimos días en Argentina, donde en un paciente “se detectó la Cándida a raíz de una infección urinaria”, y en el otro “en unas fístulas, que serían pequeños trayectos de una cirugía que no ha cerrado bien”, detalló Liliana Arce.
A quiénes afecta y qué hacer para prevenir el “super hongo”
La infectóloga aclaró que la Candida Auris frecuentemente se encuentra en “pacientes crónicos, oncológicos, en diabéticos, mayores de 75 años o en quienes tienen heridas abiertas durante mucho tiempo”.
En síntesis, las personas internadas o con factores de riesgo son las más propensas a infectarse. En este punto, remarcó la importancia de implementar los cuidados necesarios para evitarla, porque 2no es fácil aislarla y se necesitan laboratorios de alta categoría”, insistió.
Al tratarse de un hongo que usualmente se contagia en ámbitos hospitalarios, los especialistas recomiendan mantener la limpieza y desinfección en las habitaciones de los centros de salud. Del mismo modo, los familiares, médicos, o enfermeros que interactúan con los pacientes deben intensificar el lavado de manos, utilizar el traje de protección y también limpiar mesas, escritorios, objetos; toda superficie donde pueda alojarse el hongo antes de ingresar al organismo.
“El paciente tiene que estar totalmente aislado y solo, y tiene que utilizar sus propios elementos. Quien esté a cargo de su cuidado debe tomar todas las precauciones necesarias para evitar el contacto directo”, sugirió la médica.
Apuntó que la Candida Auris continúa siendo materia de investigación para la ciencia, por lo que se esperan nuevas metodologías que desarrollen un diagnóstico más rápido, al mismo tiempo que deben implementarse capacitaciones intensivas a los especialistas.
“No hay que tener miedo, hay que informarse y actuar en la prevención”, finalizó Liliana Arce.